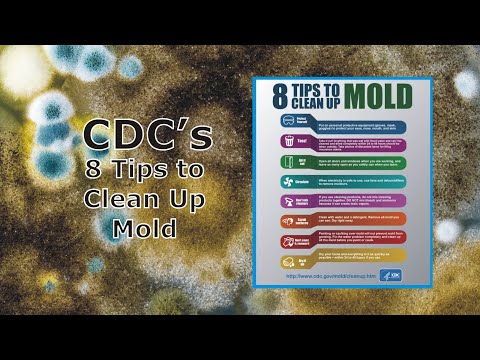

Mold Clean Up Tips from the CDC to Help Property Owners Following Water Damage
Clark Seif Clark provides testing and consulting services to identify and resolve indoor environmental quality issues associated with water damage, mold, and other microbial or chemical concerns.
Controlling moisture as both a liquid and a vapor is key to preventing indoor mold growth.
While mold is a natural part of the environment, exposure to elevated levels of it in homes, schools and businesses can be a problem. Not only can mold lower the value of a property, its presence can also lead to a number of exposure concerns for building occupants.
The Centers for Disease Control and Prevention (CDC) reports that mold can cause many health effects, including stuffy nose, sore throat, coughing or wheezing, burning eyes or a skin rash. The agency also states that people with asthma or who are allergic to mold may have severe reactions, and that immune-compromised people and people with chronic lung disease could even get lung infections from mold. Certain molds are also toxigenic, meaning they can produce toxins known as mycotoxins.
CDC has also published the infographic 8 Tips to Clean Up Mold. The tips include:
- Protect yourself - Put on personal protective equipment (gloves, mask, goggles) to protect your eyes, nose, mouth and skin.
- Toss! - Take it out! Anything that was wet with flood water and can’t be cleaned and dried out completely within 24 to 48 hours should be taken outside. Take photos of discarded items for filing insurance claims.
- Air it out - Open all doors and windows when you are working, and leave as many open as you safely can when you leave.
- Circulate - When electricity is safe to use, use fans and dehumidifiers to remove moisture.
- Don’t mix cleaners - If you use cleaning products, do not mix cleaning products together. DO NOT mix bleach and ammonia because it can create toxic vapors.
- Scrub surfaces - Clean with water and a detergent. Remove all mold you can see. Dry right away.
- Don’t cover it, remove it - Painting or caulking over mold will not prevent mold from growing. Fix the water problem completely and clean up all the mold before you paint or caulk.
- Dry it up - Dry your home and everything in it as quickly as possible – within 24 to 48 hours if possible.
“Controlling moisture as both a liquid and a vapor is key to preventing indoor mold growth,” said Derrick A. Denis, Vice President of Indoor Environmental Quality for Clark Seif Clark (CSC). “For those who encounter visible mold growth in the built environment, it may be best to allow qualified professionals to handle the situation and take the necessary steps to prevent it from recurring. Building owners, landlords, renters and homeowners concerned about exposure to mold or other indoor environmental quality (IEQ) issues can turn to the experts at CSC. We provide building inspections, consultation, testing and monitoring services. Our building science and industrial hygiene professionals can also offer remediation oversight and post remediation verification (PRV) assessments to help ensure any mold conditions are correctly resolved.”
CSC has even sponsored an educational video about the CDC’s mold clean up tips that can be seen at: https://youtu.be/U8MB2eW1bhc
To learn more about this or other indoor air quality, building science, occupational, environmental, health and safety services, please visit www.csceng.com, email csc@csceng.com or call (800) 807-1118.
About Clark Seif Clark
CSC was established in 1989 to help clients in both public and private sectors address indoor air quality, occupational, environmental, and health and safety (EH&S) issues. CSC is a leading provider of these services with multiple offices along the western seaboard and southwest. The company believes in science-based protocols and has a strong background in engineering, making them the preferred environmental consultants to industrial clients, healthcare facilities, architects, schools, builders, contractors, developers and real estate professionals.
( Press Release Image: https://photos.webwire.com/prmedia/12710/277561/277561-1.jpg )
WebWireID277561
- Contact Information
- Paul Cochrane
- President
- Cochrane & Associates, LLC
- Contact via E-mail
This news content may be integrated into any legitimate news gathering and publishing effort. Linking is permitted.
News Release Distribution and Press Release Distribution Services Provided by WebWire.